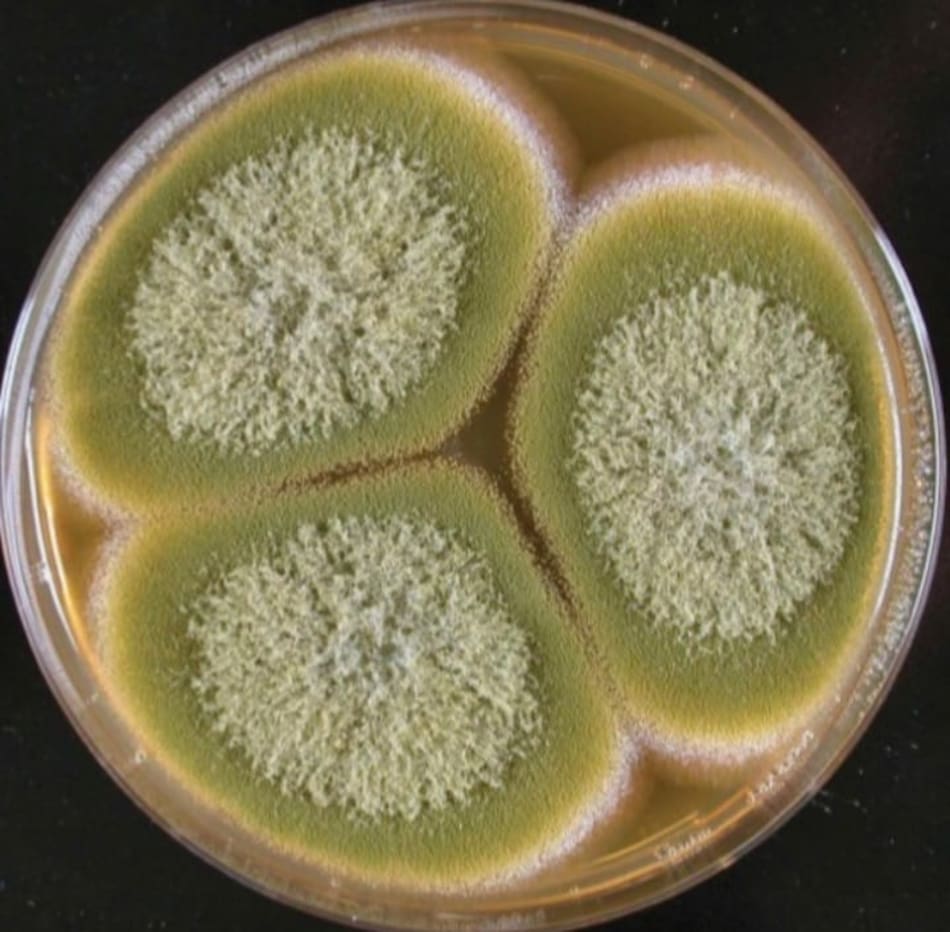

El hongo de la “maldición de Tutankamón” podría salvar vidas: descubren su potencial para combatir el cáncer

Lo que alguna vez fue símbolo de superstición y muerte, podría marcar un hito en la medicina. El Aspergillus flavus, un hongo temido por su toxicidad y vinculado con la célebre “maldición de Tutankamón”, fue transformado en un agente terapéutico con potencial para combatir ciertos tipos de cáncer.
Un equipo de científicos liderado por la Universidad de Pensilvania logró modificar químicamente las moléculas que produce este hongo, convirtiéndolas en compuestos activos contra células leucémicas.

El hallazgo, publicado esta semana en la revista Nature Chemical Biology, reveló una nueva y prometedora línea de investigación en medicamentos derivados de productos naturales.
La historia del Aspergillus flavus, el hongo tóxico que podría combatir el cáncer
Reconocido por sus esporas amarillas y su capacidad para contaminar alimentos y ambientes, su fama creció en la década de 1920, cuando varios integrantes del equipo que abrió la tumba de Tutankamón murieron repentinamente.
También podría interesarte
Décadas más tarde, en los años 70, diez científicos que ingresaron a la tumba del rey Casimiro IV en Polonia también fallecieron en cuestión de semanas. En ambos casos, la presencia de esporas fúngicas fue uno de los factores considerados.
Paradójicamente, este organismo considerado mortal dio origen a un nuevo tipo de péptido natural conocido como RiPP (péptido sintetizado por ribosomas y posteriormente modificado).
Aunque abundan en bacterias, los RiPP fúngicos son extremadamente raros. Mediante un enfoque que combinó análisis genético y metabólico, el equipo estadounidense logró aislar estas moléculas, a las que llamaron asperigimicinas, y probar su efecto contra células humanas.
Las principales conclusiones del estudio
Los resultados fueron sorprendentes: dos de las cuatro variantes purificadas inhibieron con éxito el crecimiento de células leucémicas. Una tercera, modificada con un lípido derivado de la jalea real, mostró eficacia comparable a fármacos clásicos como la citarabina.

“Estos compuestos impiden que las células se dividan, bloqueando estructuras esenciales como los microtúbulos”, explicó la profesora Sherry Gao, líder del estudio.
A diferencia de otros tratamientos agresivos, las asperigimicinas demostraron una notable selectividad, sin dañar células de otros órganos ni atacar bacterias u hongos beneficiosos. Esta especificidad las posiciona como candidatas sólidas para futuros fármacos oncológicos.
Además, el estudio identificó secuencias genéticas similares en otros hongos, lo que sugiere que aún queda un vasto universo de RiPP por descubrir. El próximo paso es evaluar la eficacia de estos compuestos en animales, antes de avanzar hacia ensayos clínicos en humanos.


















